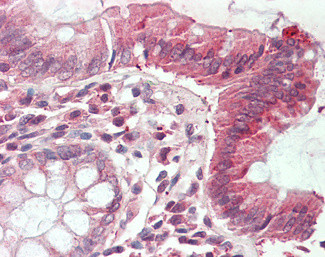
CLIC1 Antibody in Immunohistochemistry (Paraffin) (IHC (P))

Search
Invitrogen
CLIC1 Polyclonal Antibody
{{$productOrderCtrl.translations['antibody.pdp.commerceCard.promotion.promotions']}}
{{$productOrderCtrl.translations['antibody.pdp.commerceCard.promotion.viewpromo']}}
{{$productOrderCtrl.translations['antibody.pdp.commerceCard.promotion.promocode']}}: {{promo.promoCode}} {{promo.promoTitle}} {{promo.promoDescription}}. {{$productOrderCtrl.translations['antibody.pdp.commerceCard.promotion.learnmore']}}
产品信息
PA5-37850
种属反应
宿主/亚型
分类
类型
抗原
偶联物
形式
浓度
规格
纯化类型
保存液
内含物
保存条件
运输条件
RRID
产品详细信息
This antibody is predicted to react with mouse, rat, dog, pig and cow based on sequence homology.
This antibody is tested in Peptide ELISA: antibody detection limit dilution 32,000.
靶标信息
Chloride channels are a diverse group of proteins that regulate fundamental cellular processes including stabilization of cell membrane potential, transepithelial transport, maintenance of intracellular pH, and regulation of cell volume. Chloride intracellular channel 1 is a member of the p64 family; the protein localizes principally to the cell nucleus and exhibits both nuclear and plasma membrane chloride ion channel activity.
仅用于科研。不用于诊断过程。未经明确授权不得转售。
篇参考文献 (0)
生物信息学
蛋白别名: 27kDa protein; Chloride channel ABP; Chloride intracellular channel protein 1; CLIC1; DADB-110M10.1; FLJ94671; Glutaredoxin-like oxidoreductase CLIC1; Glutathione-dependent dehydroascorbate reductase CLIC1; hRNCC; NCC27; Nuclear chloride ion channel 27; nuclear chloride ion channel protein; p64 CLCP; p64CLCP; Regulatory nuclear chloride ion channel protein; RNCC protein; unnamed protein product
基因别名: CL1C1; CLCNL1; CLIC1; G6; NCC27
UniProt ID: (Human) O00299
Entrez Gene ID: (Human) 1192